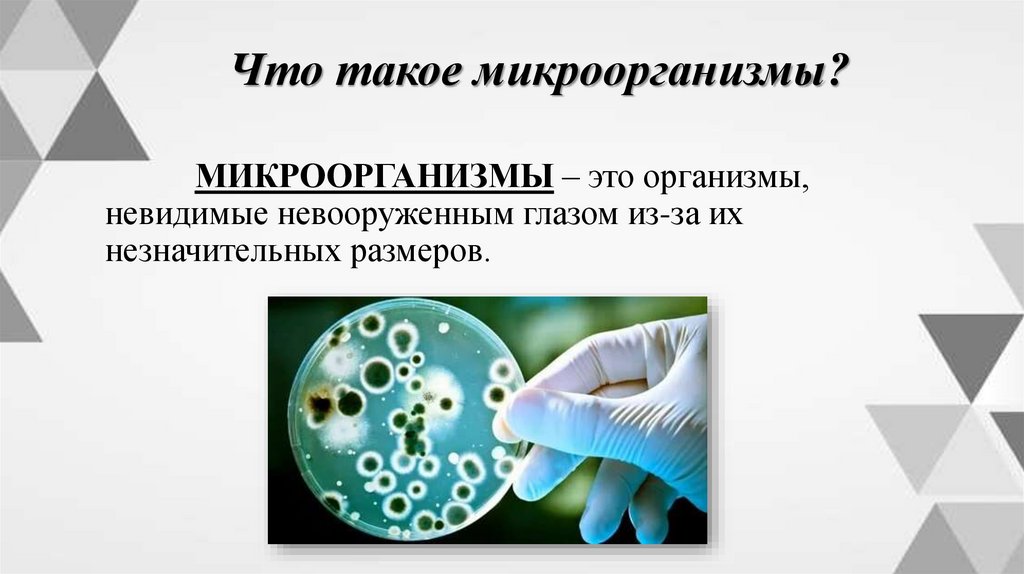
Что такое микроорганизмы?

Похожие презентации:
Введение в микробиологию. Микробиология, физиология питания, санитария и гигиена
1. Микробиология, физиология питания, санитария и гигиена
2. Тема урока Введение в микробиологию
3.
Дорожная карта урока1. Что такое
микробиология
2. Микробиология и
история ее развития
3. Виды
микроорганизмов
4. Классификация
микроорганизмов.
4. Что такое микробиология?
МИКРОБИОЛОГИЯ (от греч. micros малый, bios - жизнь, logos - учение) - наука,изучающая строение, жизнедеятельность и
экологию микроорганизмов - мельчайших форм
жизни растительного или животного
происхождения, невидимых невооруженным
глазом.
Она изучает всех представителей микромира
(бактерии, грибы, вирусы).
5. Что такое микроорганизмы?
МИКРООРГАНИЗМЫ – это организмы,невидимые невооруженным глазом из-за их
незначительных размеров.
6.
7.
Микроорганизмы повсеместнораспространены в природе: в почве, водоемах,
воздухе, находятся на продуктах питания и всех
предметах, окружающих человека.
Микроорганизмы выполняют колоссальную
работу: они разлагают растительные и животные
остатки на поверхности планеты, используются в
технологии производства многих пищевых
продуктов, различных биологически активных
соединений.
8. МИКРОБИОЛОГИЯ И ИСТОРИЯ ЕЕ РАЗВИТИЯ
Первым человеком, увидевшиммикроорганизмы, был голландец
Антони ван Левенгук (1632-1723).
Он смог подтвердить на практике
существовавшее до этого лишь в
теории знание о них.
Он сконструировал микроскоп,
который увеличивал предметы в 300
раз.
9. МИКРОБИОЛОГИЯ И ИСТОРИЯ ЕЕ РАЗВИТИЯ
Рассматривая подмикроскопом различные объекты
(дождевую воду, кровь), он
обнаружил мельчайших
«животных», и был убежден, что
они устроены так же, как и
крупные организмы, то есть
имеют такие же органы, но
только очень маленькие.
10.
Открытие Антони ван Левенгукаподтвердило повсеместное распространение
микроорганизмов, описаны формы клеток,
характер движения, места обитания многих
представителей микромира.
11. МИКРОБИОЛОГИЯ И ИСТОРИЯ ЕЕ РАЗВИТИЯ
А. Левенгук, открывший мирмикроскопических живых существ, считал,
что они являются «маленькими живыми
зверушками».
12. Луи Пастер
Французский ученыйЛуи Пастер (1822 -1895 гг.),
своими работами положил
начало современной
микробиологии. Пастер
установил, что
микроорганизмы
различаются не только по
внешнему виду, но и по
характеру
жизнедеятельности.
Пастер впервые обнаружил
бактерии, не способные
развиваться в присутствии
воздуха, т.е. показал, что жизнь
возможна и без кислорода.
13. Луи Пастер
Пастеризация – это тепловая обработка сырья дотемпературы 60—70°, при которой погибают
вредные микроорганизмы, но сохраняются вкусовые
качества продуктов и витамины.
14. Луи Пастер
Пастер открыл природу инфекционных болезнейчеловека и животных, установил, что эти болезни
возникают вследствие заражения особыми микробами и
что каждое заболевание вызывается определенным
микроорганизмом.
Он разработал и научно обосновал метод
предупреждения заразных болезней, изготовил
вакцины против бешенства и сибирской язвы.
15. Роберт Кох
Роберт Кох. Немецкиймикробиолог _ Russian
(360p).mp4
16. Роберт Кох
Значительным вкладом в микробиологию сталиисследования немецкого ученого Роберта Коха (1843-1910
гг.). Им были введены в микробиологическую практику
плотные питательные среды для выращивания
микроорганизмов, что привело к выращиванию массы
клеток каждого вида в отдельности. Р. Кох открыл (1882 г.)
возбудителя туберкулеза, названного его именем –
«палочкой Коха».
17. Илья Ильич Мечников
Развитие микробиологиинеразрывно связано с работами
русских ученых.
Родоначальником русской
микробиологии считается И.И.
Мечников (1845-1916 гг.), работы
которого положили начало новому
этапу в развитии науки.
18. Илья Ильич Мечников
Центральной проблемой его исследованийбыло изучение взаимоотношений паразита и
хозяина – человека.
Он создал теорию иммунитета, в основе
которой лежит способность микроорганизма
противостоять инородным телам, в том числе и
болезнетворным микробам, что явилось основой
науки об антибиотиках.
19. Виды микроорганизмов
Прокариоты –организмы, состоящие из
клеток, которые не имеют
клеточного ядра.
Прокариоты создают
царство бактерий,
одноклеточных организмов.
Эукариоты – это ядерные
клетки.
Эукариоты образуют 3
царства: грибы, растения и
животные. Эти группы
включают многоклеточные и
одноклеточные организмы.
20. Виды микроорганизмов
21. Классификация микроорганизмов
22. Вопросы для контроля знаний
1. Что такое микробиология?2. Кто изобрел микроскоп?
3. Во сколько раз увеличивал микроскоп?
4. Возбудителя какой болезни открыл Роберт Кох?
5. Что установил Луи Пастер?
6. Перечислите виды микроорганизмов.
7. Назовите классификацию микроорганизмов.

Биология
Биология








